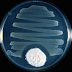

The Celiac Student
Recipes + Science + Geekiness = Yes
Pages
▼
Tuesday, December 21, 2010
Sunday, December 5, 2010
Tuesday, November 9, 2010
Saturday, November 6, 2010
Sunday, October 3, 2010
Wednesday, September 1, 2010